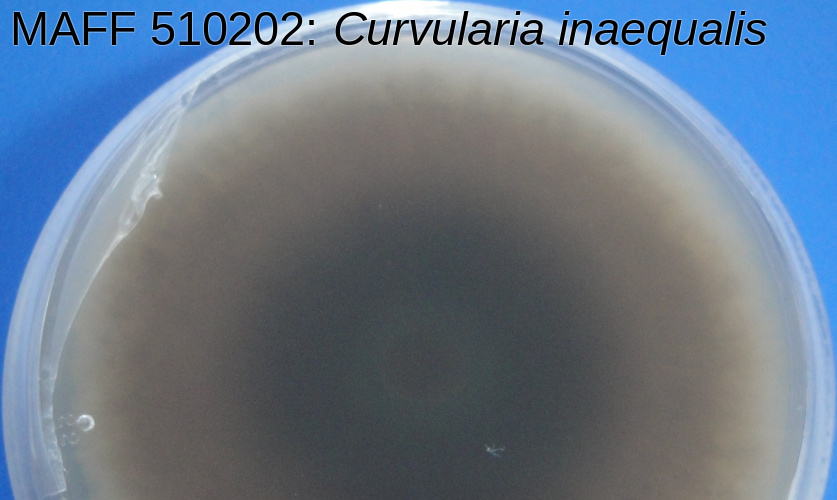
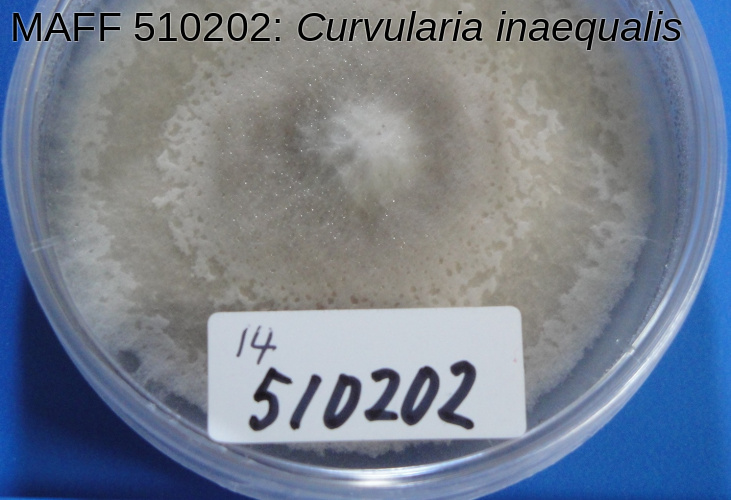

MAFF 510202の詳細
| MAFF番号 | 510202 |
|---|
| 微生物種類 | 糸状菌 |
|---|
| 学名 | Curvularia inaequalis (Shear) Boedijn |
|---|
| 分類検証 | ✔分子系統データ等により、この表示学名の妥当性が検証されています。 |
|---|
| 再同定者 | 青木孝之 (更新: 2017/01) |
|---|
| 登録時学名 | Curvularia geniculata (Tracy et Earle) Boedijn |
|---|
| 同定者 | 江原 |
|---|
| 分離源 | のしば |
|---|
| 分離者 | 江原 |
|---|
| 提供者 | 君ヶ袋尚志 |
|---|
| 塩基配列 | ITS |
|---|
| 写真データ | |
|---|
| 配布申込 | 申込 |
|---|